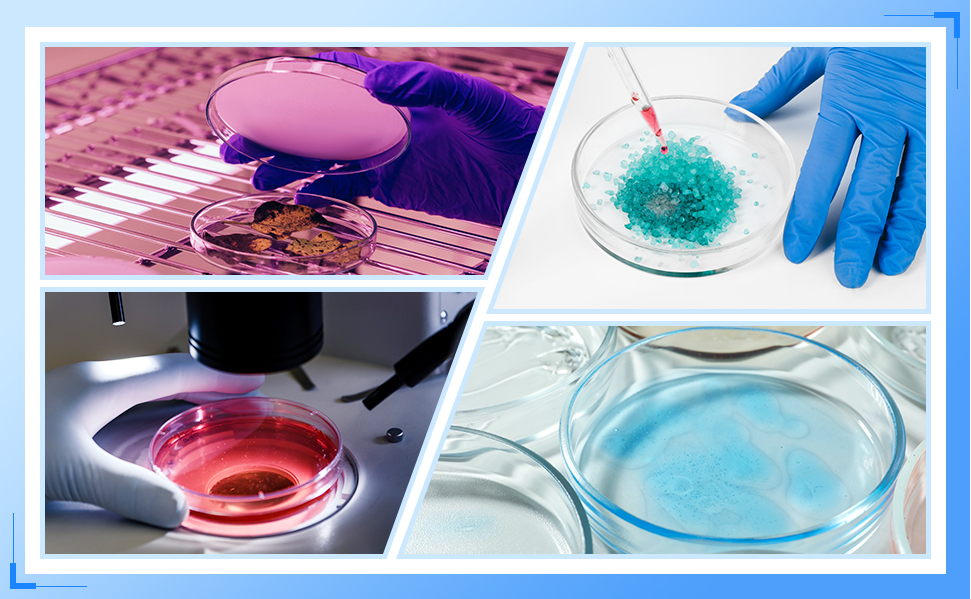
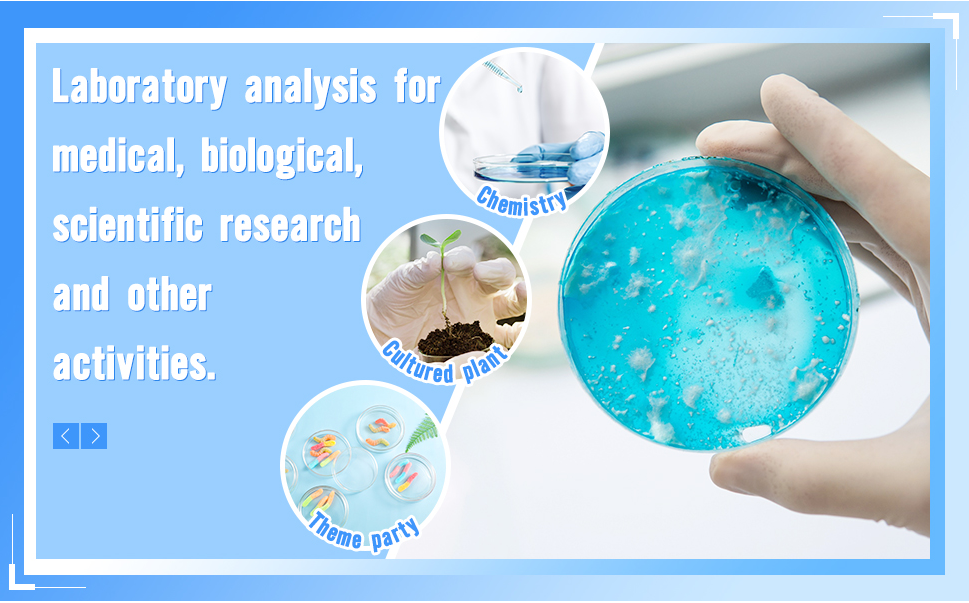

the glass petri dishes are made of borosilicate glass, which are transparent, easy to clean and reusable; They can withstand high temperature up to 300℃, but cannot be applied for heating
Small size
Small size
the outside diameter with the lid included of the glass petri dish is 90mm/ 3.54 inches and the height is 20mm/ 0.79 inches; The diameter of the lid is a little larger than the plate to allow air circulation
.